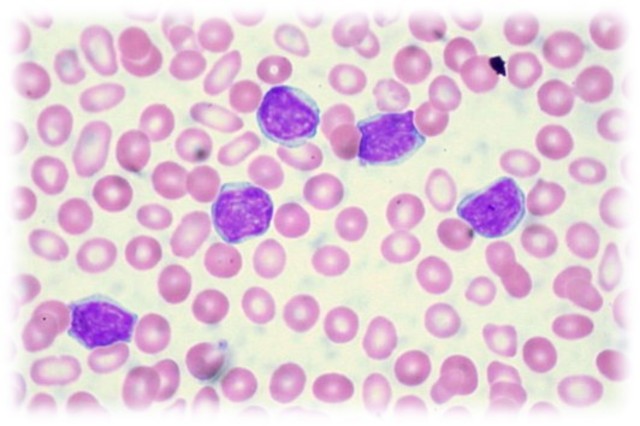
LA TERAPIA GÉNICA CONTRA LA LEUCEMIA

-
Calificado como el invento científico del siglo, se puso en funcionamiento en el CERN de Ginebra el Gran Colisionador de Hadrones, el acelerador de partículas más potente del mundo. El objetivo del experimento era reproducir las condiciones que existían inmediatamente después del Big Bang, con la intención de desentrañar los grandes enigmas que siguen rodeando a la naturaleza de la materia. Sin embargo, una avería durante las primeras horas obligó a detener y aplazar el experimento.
-
Un superordenador de 133 millones de dólares llamado Roadrunner fabricado por IBM superaba todos los récords de velocidad anteriores alcanzando por primera vez la marca del petaflop (es decir, mil billones, o 10 elevado a 15, o un 1 seguido de 15 ceros) de operaciones por segundo. Se calcula que los 6.000 millones de personas que hay en la Tierra, provistas de calculadoras caseras y trabajando sin interrupción, tardarían 46 años en completar los cálculos el 'Correcaminos' realiza en un día.
-
El telescopio espacial Fermi de rayos Gamma de la NASA ha permitido detectar pulsares –estrellas neutrónicas magnéticas y de rápida rotación–, un proyecto en el que participan investigadores del CSIC. El telescopio fue puesto en órbita en 2008 y su mayor éxito es haber proporcionado una medida que constituyó una prueba empírica sobre la teoría de la relatividad.
-
Un grupo de investigadores ha desarrollado una nueva técnica de dimensiones nanométricas, para alimentar dispositivos sin necesidad de utilizar voluminosas fuentes de energía, tales como las baterías convencionales. Con un desarrollo adecuado funcionarán convirtiendo la energía mecánica del movimiento del cuerpo, la contracción de los músculos o el flujo del agua, en electricidad.
-
os pruebas de prevención del VIH, con estrategias nuevas y diferentes dieron como resultado un éxito inequívoco: un gel vaginal que contiene el fármaco anti-VIH Tenofovir reduce las infecciones en mujeres en un 39% y una profilaxis de de pre-exposición oral llevó a un 43,8% menos de infecciones de VIH en un grupo de hombres y mujeres transgenéricas que mantienen relaciones sexuales con hombres.
-
Lanzado primeramente en Estados Unidos, el 4 de noviembre de 2010, es esencialmente un sensor horizontal conectado a una pequeña base colocada debajo o encima de la pantalla, capaz de pleno reconocimiento del cuerpo en movimiento, y en tercera dimensión.
Todo esto, unido a la capacidad para reconocer la voz y los rasgos faciales, Kinect es una verdadera revolución en el mundo de las consolas de videojuegos ya que no se necesitan más controles físicos que el propio cuerpo del jugador. -
Un experimento logró retrasar en ratones los síntomas de la vejez, como son las arrugas, cataratas y el desgaste muscular. Científicos estadounidenses descubrieron que con la edad las células senescentes se acumulan en el organismo, porque dejan de dividirse, y su eliminación puede ser la clave para ayudar a que la gente permanezca sana durante más tiempo cuando envejece, indica el estudio publicado por ‘Science’.
-
Tuvo un importante desarrollo este año a pesar de que esta tecnología existía hace ya un tiempo. Para más adelante, podrían realizarse operaciones de renderización desde la nube y así distribuirlas a dispositivos de bajo poder gráfico, a través de la banda ancha. Cada día más empresas adoptan por esta modalidad de trabajo que les permite acceder a sus archivos a cualquier hora desde cualquier ubicación.
-
El escáner de retina es una técnica biométrica que permite identificar a una persona a través de los patrones únicos e individuales observados en ese tejido del ojo humano. Estos dispositivos consistían en grandes y complejas máquinas y su uso estaba restringido a corporaciones gubernamentales, con propósitos médicos o de seguridad, este año una compañía puertorriqueña anunció el primer escáner de retina portátil disponible en el mercado.
-
Un equipo internacional de científicos utilizó un innovador láser de rayos X en el Laboratorio del Acelerador Nacional SLAC (California, EE.UU) para revelar la estructura de una enzima clave que permite al parásito Trypanosoma brucei causar la enfermedad del sueño en África.
-
a mediados de septiembre, los cientificos de la nasa anunciaron que los instrumentos de la sonda voyager que esta se habia movido mas alla de la burbuja de gas caliente que emite nuestro sol y ahora se desplaza en el espacio, entre las estrellas.
lo que significa que es el mejor objeto hecho por el hombre que abandona el sistema solar y se adentra en el inexplorado espacio exterior. -
Un experto en neurociencias afirma que ha descifrado el código que utiliza el cerebro para formular recuerdos a largo plazo. Actualmente está haciendo pruebas para desarrollar un implante protésico para personas que sufren pérdida de memoria
-
En el 2014, dos grupos de científicos crearon métodos para crear, a partir de células embrionarias humanas, células beta del páncreas, funcionales ciento por ciento para producir insulina. Las células beta del páncreas son destruidas por el mismo sistema inmune de pacientes con diabetes tipo 1.
-
Según el MIT los drones para la agricultura son una tecnología rompedora que permite aumentar la producción de las cosechas sin provocar daños, hacer un seguimiento del cultivo, mejorar el consumo de agua y gestionar las plagas gracias a las cámaras incorporadas.
-
Su funcionamiento, como explicó a Hipertextual la Dra. Jennifer Doudna, recuerda a un "bisturí molecular" para editar el genoma. Aunque la publicación del sistema CRISPR-Cas9 en la revista Science se produjo en 2012, esta nueva técnica de ingeniería genética ha sido uno de los mejores avances de la ciencia en 2015.
-
La inteligencia artificial (IA), a diferencia del hardware y el software normales, permite a una máquina percibir y responder al entorno cambiante que la rodea. La IA emergente lleva esto un paso más allá, dando lugar a máquinas que aprenden automáticamente asimilando grandes volúmenes de información.
-
Pero este año nos llegaron los resultados de una prueba sin precedentes. Los investigadores de la Universidad de Southhampton lograron disolver carbón atmosférico en agua y sellarlo en un pozo subterráneo en Islandia. Luego de dos años, el carbón reaccionó a los minerales basálticos, y eventualmente se cristalizó en una forma sólida, que permanecerá así por siglos o incluso milenios.
-
se han dado a conocer múltiples dispositivos destinados a hacer nuestro hogar más inteligente, desde un cabezal de ducha que nos avisa cuando estamos gastando demasiada agua, a una lavadora-secadora inteligente, conectada al Internet de las cosas, que es capaz de pedir más detergente al servicio de reposición Dash de Amazon cuando detecta que se están acabando las existencias en el hogar.
-
El químico David Liu, de la Universidad de Harvard, ha modificado la caja de herramientas de CRISPR para crear un editor de bases que, tras lograr el año pasado reemplazar una citosina (C) errónea por una timina (T), en 2017 ha conseguido cambiar una guanina (G) incorrecta –la mutación puntal más común– en una adenina (A). Por su parte, el equipo de Feng Zhang en el Broad Institute sustituyó una G por una A en ARN.
-
Un tipo de terapia génica para el cáncer (terapia CAR-T) recibió en septiembre luz verde de la Agencia de Alimentos y Medicamentos de Estados Unidos (FDA, por sus siglas en inglés) para su aplicación en humanos. Se aprobó Kymriah (tisagenlecleucel) para ciertos pacientes pediátricos y adultos jóvenes con una forma de leucemia linfoblástica aguda (ALL).
-
Investigadores de la Universidad de Cambridge crearon estructuras similares a las de un embrión sin necesitar de óvulos o espermatozoides, solo células madre. Este logro no solo incentiva una nueva investigación del origen de la vida, sino también a un replanteo de los debates bioéticos.
-
La tecnología aplicada a la salud de uso personal está ganando cada vez más terreno. La firma La Roche-Posay presentó una especie de sticker electrónico diminuto que se aplica en la piel para medir los rayos UV y prevenir enfermedades dermatológicas. Mide 2 mm por 9 mm. Se puede aplicar en una uña, un brazo, o cualquier parte del cuerpo que esté expuesta al sol. A través de una aplicación disponible para iOS y Android transmite información para cuidar la piel y es reutilizable.
Want to make a timeline like this?
Use Timetoast to turn dates, events, milestones, and phases into a clear visual timeline you can build and share. Timetoast is a timeline maker for work, school, research, and stories.